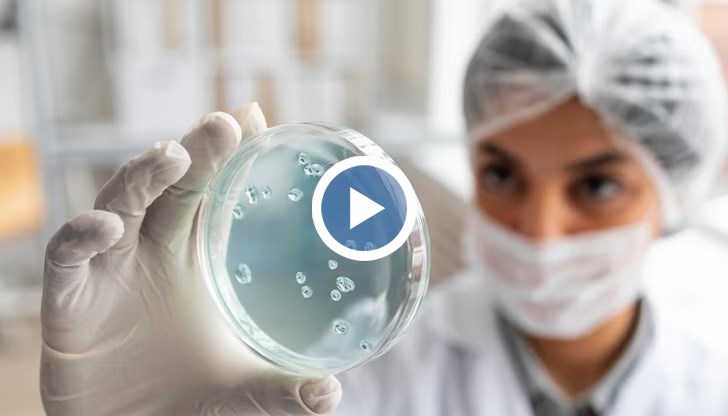
Вирусите, убиващи ракови клетки, са известни от повече от век

Как вирусите помагат срещу онкологичните заболявания?
- Редактор: Диляна Маринова
- Коментари: 0
Вирусите, убиващи ракови клетки, са известни от повече от век
Вирусите - тези инфекциозни агенти, идентифицирани днес като "обществен враг № 1", изглежда могат да станат съюзници срещу раковите патологии.
Онколитичните вируси, буквално - вируси, убиващи ракови клетки, са известни от повече от век благодарение на първия случай, описан през 1904 г., на пациент с миелоидна левкемия в ремисия, след като вероятно е бил заразен от грип, предава NOVA.
Независимо дали са мутирали или от див тип, тези вируси имат предимството да се реплицират преференциално в туморни клетки и да водят до тяхната регресия чрез клетъчен лизис и стимулиране на туморния имунен отговор.























